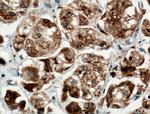
TGN46 Antibody in Immunohistochemistry (Paraffin) (IHC (P))

Search
Proteintech
TGN46 Monoclonal Antibody (1F6D5)
{{$productOrderCtrl.translations['antibody.pdp.commerceCard.promotion.promotions']}}
{{$productOrderCtrl.translations['antibody.pdp.commerceCard.promotion.viewpromo']}}
{{$productOrderCtrl.translations['antibody.pdp.commerceCard.promotion.promocode']}}: {{promo.promoCode}} {{promo.promoTitle}} {{promo.promoDescription}}. {{$productOrderCtrl.translations['antibody.pdp.commerceCard.promotion.learnmore']}}
图: 1 / 6
TGN46 Antibody (66477-1-IG) in ICC/IF

产品信息
66477-1-IG
种属反应
宿主/亚型
分类
类型
克隆号
抗原
偶联物
形式
浓度
规格
纯化类型
保存液
内含物
保存条件
运输条件
产品详细信息
Immunogen sequence: SVKQEEAGV RPSAGNVSTH PSLSQRPGGS TKSHPEPQTP KDSPSKSSAE AQTPEDTPNK SGAEAKTQKD SSNKSGAEAK TQKGSTSKSG SEAQTTKDST SKSHPELQTP KDSTGKSGAE AQTPEDSPNR SGAEAKTQKD SPSKSGSEAQ TTKDVPNKSG ADGQTPKDGS SKSGAEDQTP KDVPNKSGAE KQTPKDGSNK SGAEEQGPID GPSKSGAEEQ TSKDSPNKVV PEQPSRKDHS KPISNPSDNK ELPKADTNQL ADKGKLSPHA FKTESGEETD LISPPQEEVK SSEPTEDVEP KEAEDDDTGP EEGSPPKEEK EKMSGSASSE NREGTLSDST GSEKDDLYPN GSGNGSAESS H (25-384 aa encoded by BC028219)
靶标信息
IASPP is one of the most evolutionarily conserved inhibitors of p53 (TP53; MIM 191170), whereas ASPP1. and ASPP2. are activators of p53.
仅用于科研。不用于诊断过程。未经明确授权不得转售。
生物信息学
蛋白别名: hTGN48; hTGN51; similar to rat TGN38; TGN38 homolog; TGN38B; TGN46; Trans-Golgi network glycoprotein 46; Trans-Golgi network glycoprotein 48; Trans-Golgi network glycoprotein 51; Trans-Golgi network integral membrane protein 2; Trans-Golgi network integral membrane protein TGN38; trans-golgi network protein 1; Trans-Golgi network protein 2; trans-Golgi network protein TGN51; unnamed protein product
基因别名: hTGN46; hTGN48; hTGN51; TGN38; TGN38B; TGN41; TGN46; TGN48; TGN51; Tgoln1; TGOLN2; Ttgn1; TTGN2
UniProt ID: (Human) O43493, (Rat) Q4G0B6, (Mouse) Q62314
Entrez Gene ID: (Human) 10618, (Rat) 192152, (Mouse) 22135




